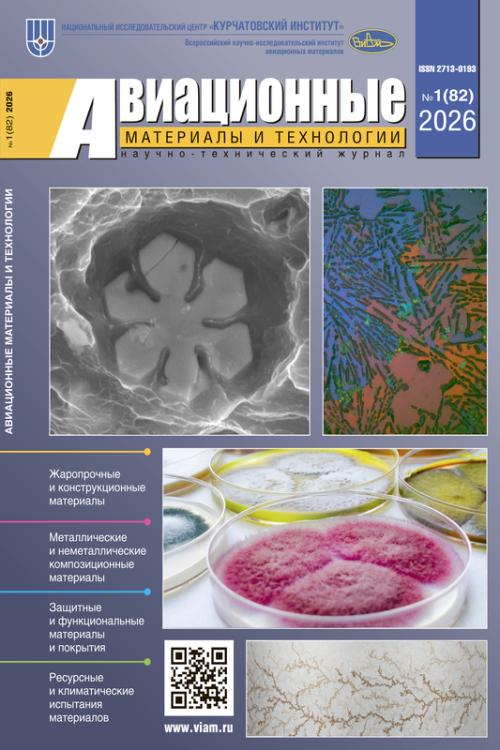

НАУЧНО-ТЕХНИЧЕСКИЙ ЖУРНАЛ «АВИАЦИОННЫЕ МАТЕРИАЛЫ И ТЕХНОЛОГИИ»
Вышел в свет первый в 2026 году номер научно-технического журнала «Авиационные материалы и технологии».
В журнале представлены результаты оригинальных исследований, а также обзоры по разработкам ученых НИЦ «Курчатовский институт» – ВИАМ и других организаций отрасли в различных областях современного материаловедения.
В новом выпуске авторы публикаций рассматривают вопросы получения отливок неохлаждаемых турбинных лопаток из жаропрочного сплава ВЖЛ21; исследуют особенности технологии электродуговой наплавки проволоки для синтеза деталей из стали ВНС-2; анализируют магнитные свойства мартенситно-стареющей стали 21НКМТ после различных видов обработки; изучают влияние дисперсного состава и количества наполнителя на физико-механические свойства стеклокерамического композиционного материала, обсуждают перспективы использования цирконата гадолиния в качестве керамического слоя теплозащитного покрытия и другие вопросы.
Напомним, что электронный научно-технический сборник «Авиационные материалы и технологии» выпускается ежеквартально, категория Перечня ВАК – 1 (К1), уровень Белого списка – 2 (У2).
Ознакомиться с условиями подписки и с информацией для авторов публикаций можно на сайте журнала.
